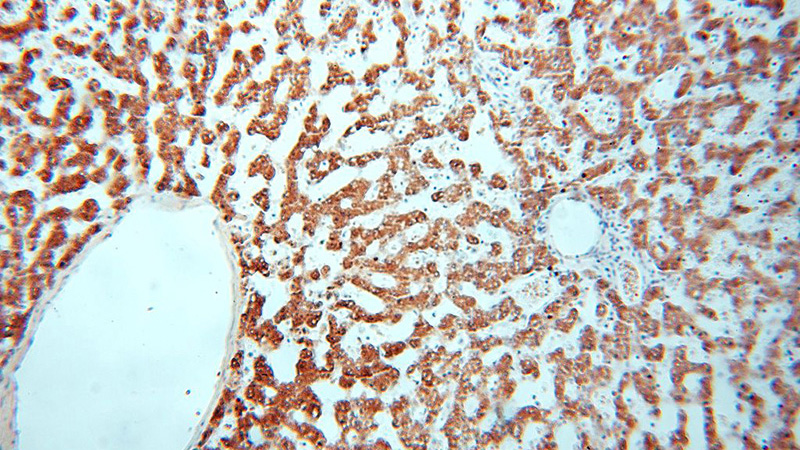
Immunohistochemical of paraffin-embedded human liver using Catalog No:109192(CES1 antibody) at dilution of 1:200 (under 10x lens)

-
Product Name
CES1 antibody
- Documents
-
Description
CES1 Rabbit Polyclonal antibody. Positive IHC detected in human liver tissue, human kidney tissue, human ovary tissue. Positive WB detected in HEK-293 cells, Jurkat cells. Observed molecular weight by Western-blot: 62kd
-
Tested applications
ELISA, WB, IHC
-
Species reactivity
Human; other species not tested.
-
Alternative names
ACAT antibody; Brain carboxylesterase hBr1 antibody; CEH antibody; CES1 antibody; CES2 antibody; COCaine carboxylesterase antibody; Egasyn antibody; HMSE antibody; HMSE1 antibody; Liver carboxylesterase 1 antibody; PCE 1 antibody; REH antibody; Retinyl ester hydrolase antibody; Serine esterase 1 antibody; SES1 antibody; TGH antibody; Triacylglycerol hydrolase antibody
-
Isotype
Rabbit IgG
-
Preparation
This antibody was obtained by immunization of CES1 recombinant protein (Accession Number: NM_001266). Purification method: Antigen affinity purified.
-
Clonality
Polyclonal
-
Formulation
PBS with 0.02% sodium azide and 50% glycerol pH 7.3.
-
Storage instructions
Store at -20℃. DO NOT ALIQUOT
-
Applications
Recommended Dilution:
WB: 1:200-1:2000
IHC: 1:20-1:200
-
Validations

HEK-293 cells were subjected to SDS PAGE followed by western blot with Catalog No:109192(CES1 antibody) at dilution of 1:500
Immunohistochemical of paraffin-embedded human liver using Catalog No:109192(CES1 antibody) at dilution of 1:200 (under 10x lens)

Immunohistochemical of paraffin-embedded human liver using Catalog No:109192(CES1 antibody) at dilution of 1:200 (under 40x lens)
-
Background
CES1(liver carboxylesterase 1) is also named as CES2, SES1 and belongs to the type-B carboxylesterase/lipase family. The deduced 567-amino acid protein contains a putative 18-amino acid signal peptide and a characteristic C-terminal endoplasmic reticulum retention signal (HXEL). It is the major hydrolytic enzyme responsible for the metabolism of numerous therapeutic agents as well as endogenous substrates.Westernblot analysis demonstrated that CES1 is expressed in human liver microsomes (HLM) but not in human intestinal microsomes (HIM)(PMID:19185566).
-
References
- Sato Y, Miyashita A, Iwatsubo T, Usui T. Simultaneous absolute protein quantification of carboxylesterases 1 and 2 in human liver tissue fractions using liquid chromatography-tandem mass spectrometry. Drug metabolism and disposition: the biological fate of chemicals. 40(7):1389-96. 2012.
- Verbrugge SE, Al M, Assaraf YG. Multifactorial resistance to aminopeptidase inhibitor prodrug CHR2863 in myeloid leukemia cells: down-regulation of carboxylesterase 1, drug sequestration in lipid droplets and pro-survival activation ERK/Akt/mTOR. Oncotarget. 2015.
Related Products / Services
Please note: All products are "FOR RESEARCH USE ONLY AND ARE NOT INTENDED FOR DIAGNOSTIC OR THERAPEUTIC USE"
